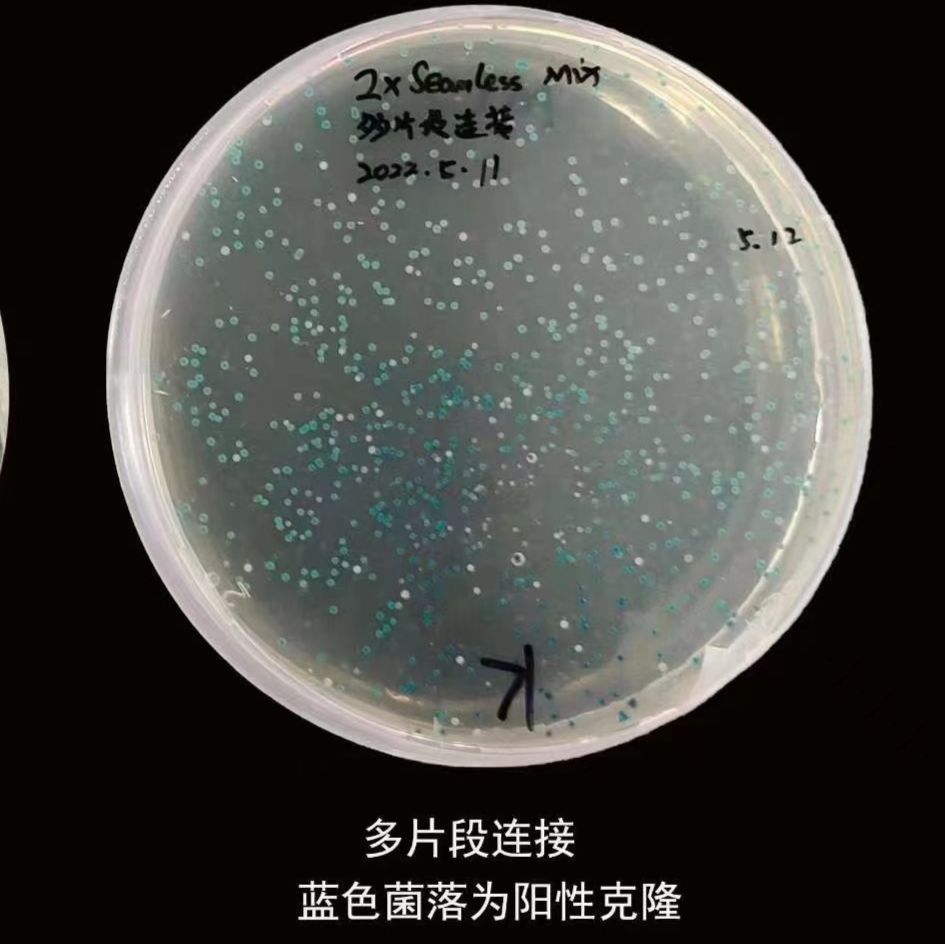
DH5α-大肠杆菌感受态细胞

相关产品推荐更多 >
万千商家帮你免费找货
0 人在求购买到急需产品
- 详细信息
- 文献和实验
- 技术资料
- 库存:
大量
- 英文名:
DH5α-大肠杆菌感受态细胞
- 保质期:
6个月
- 供应商:
南京万木春
- 保存条件:
-70度
- 规格:
10×100ul/20×100ul
| 规格: | 10×100ul | 产品价格: | ¥240.0 |
|---|---|---|---|
| 规格: | 20×100ul | 产品价格: | ¥420.0 |
DH5α- 大肠杆菌感受态细胞
产品信息:
组成 BC116-01 BC116-02
DH5α- Competent cells 10×100µl 20×100µl
pUC19(0.1ng/µl) 5µl 5µl
储存条件:-70℃保存,避免反复冻融。
产品介绍:
DH5α-菌株是实验室最常用的感受态细胞。缺失核酸内切酶 (endA1),提高了质粒 DNA 的产量和质量;
重组酶缺陷型(recA1)减少插入片段的同源重组概率,保证了插入 DNA 的稳定性;由于 lacZΔM15 的存在以及
lac lq 基因的缺失,故不需要加 IPTG,只需要添加 X-gal 就可进行基于α互补原理上的蓝白斑筛选实验。感受
态细胞经特殊工艺制作,pUC19 质粒检测转化效率大于 10 8 cfu/μg。
基因型:
F -φ80dlacZ ΔM15,Δ(lacZYA -argF )U169 deoR, recA1endA1hsdR17 (rK -, mK + ) phoAsupE44 λ -thi -1gyrA96 relA1
产品特点:
缺失核酸内切酶(endA1),提高了质粒 DNA 的产量和质量;重组酶缺陷型(recA1)减少插入片段的同源重
组概率,保证了插入 DNA 的稳定性;由于 lacZΔM15 的存在以及 lac I q 基因的缺失,故不需要加 IPTG,只需
要添加 X-gal 就可进行基于α互补原理上的蓝白斑筛选实验。
操作步骤(以下操作均按无菌条件的标准进行):
提示
感受态细胞应保存在-70℃,不可多次冻融和放置时间过长,以避免降低感受态细胞的转化效率。
进行转化操作时,应根据相应温度及无菌条件的要求进行。
为防止转化实验不成功,可以保留部分连接反应液,以重新转化,将损失降到最低。
1. 取感受态细胞置于冰浴中,如需分装可将刚融化细胞悬液分装到无菌预冷的离心管中,置于冰浴中。
(一次转化感受态细胞的建议用量为 50-100μl,可以根据实际情况分装使用。应注意所用 DNA 体积
不要超过感受态细胞悬液体积的十分之一。)以下实验以 100μl 感受态细胞为例。
2. 向感受态细胞悬液中加入目的 DNA,轻轻旋转离心管以混匀内容物,在冰浴中静置 30 分钟。
3. 将离心管置于 42℃水浴中放置 60 秒,然后快速将管转移到冰浴中,使细胞冷却 2 分钟,该过程不要摇
动离心管。(此步骤也可将离心管置于室温进行,时间不需十分准确,夏季或室温较高时,可放置 5-8
分钟左右;如果室温较低,可延长时间至 8-15 分钟左右。条件允许建议使用 42℃热激方法。)
4. 向每个离心管中加入 500μl 无菌的 SOC 或 LB 培养基(不含抗生素),混匀后置于 37℃ 150rpm,摇床
振荡培养 60 分钟,目的是使质粒上相关的抗性标记基因表达,使菌体复苏。
5. 无菌条件下,取适量菌液加到含相应抗生素的 LB 固体培养基平板上,用无菌的细菌涂布器或玻璃珠将
细胞均匀涂开。等平板中的液体完全吸收后,倒置平板,37℃培养 12-16 小时。(涂布用量可根据具
体实验来调整。转化质粒在 10ng 左右,90mm 平皿涂布 100µl,55mm 平皿涂布 50µl;连接产物的转
化菌液建议离心后倒掉大部分上清,余 200µl,取 100µl 用于涂布。)
6. 保留剩余的菌液于 4℃冰箱中,视平板上菌落生长情况决定去留。
(质粒快速转化步骤:将步骤 2 的时间缩短到 5 分钟,对于氨苄青霉素抗性的质粒,步骤 3 完成后,可
直接涂布或划线于含氨苄青霉素抗性的 LB 平板上。其它抗性的质粒仍需 60 分钟的复苏培养。)
相关试剂及培养基的制备方法:
1. LB 液体培养基:称取 10g Tryptone,5g Yeast Extract 和 10g NaCl 置于 1L 烧杯中。加入约 800ml 的去
离子水,完全溶解后用 2mol/L 的 NaOH 溶液调节 pH 值至 7.0。加去离子水定容至 1L。分装后,121℃
高压灭菌 20 分钟。
2. SOB 和 SOC 培养基:称取 20g Tryptone,5g Yeast Extract,0.5g NaCl 置于 1L 烧杯中加入约 800ml 的去
离子水,完全溶解后再补加 10ml 250mM KCl 溶液,滴加 5M NaOH(约 0.2ml)调 pH 至 7.0。加入去
离子水将培养基定容至 1L。121℃灭菌 20 分钟。使用时加入 5ml 灭菌的 2M MgCl2 溶液(此种培养基
称为 SOB)。再补加经 0.22µm 过滤除菌的 1M 葡萄糖溶液 2ml(此种培养基为 SOC)。
3. 转化复苏细菌用的液体 LB 培养基或 SOC 培养基:可以一次高压 50ml 液体培养基,无菌状态按 1ml
每管分装于高压灭菌的 1.5ml 离心管中,装于自封袋中,冻存于-20℃中,每次用一支。可以极大地避
免培养基污染和减少劳动量。
4. LB 固体选择培养基:100ml LB 液体培养基中加入 1.5g 琼脂粉,摇匀后,121℃高压灭菌 20 分钟。冷
却至 50℃左右时加入相应浓度的抗生素(如 AMP 浓度通常为 100µg/ml),混匀后倒在细菌用的无菌培
养皿中,等琼脂凝固后即可使用。
5. IPTG:称量 1.9g IPTG(MW=238.31)充分溶解于 40 ml 灭菌水,浓度为 200mmol/L。用无菌 0.22μm
过滤膜过滤除菌。小份分装后,-20℃保存。
6. X-gal:用 DMF(二甲基甲酰胺)配制成 20mg/ml,小份分装(1ml/份)后,-20℃避光保存。
E 、感受态细胞 | |||
| E-1 、大肠杆菌克隆感受态细胞 | |||
| 货号 | 产品名称 | 规格 | 单位 |
| BC101-01 | TOP10 感受态细胞 | 100μl ×10 | 包 |
| BC101-02 | 100μl ×20 | 包 | |
| BC102-01 | DH5α 感受态细胞 | 100μl ×10 | 包 |
| BC102-02 | DH5α 感受态细胞 | 100μl ×20 | 包 |
| BC103-01 | JM109 感受态细胞 | 100μl ×10 | 包 |
| BC103-02 | 100μl ×20 | 包 | |
| BC104-01 | XL1-Blue 感受态细胞 | 100μl ×10 | 包 |
| BC104-02 | 100μl ×20 | 包 | |
| BC105-01 | Mach 1-T1 感受态细胞 | 100μl ×10 | 包 |
| BC105-02 | 100μl ×20 | 包 | |
| BC117-01 | Turbo 感受态细胞 | 100ul ×10 | 包 |
| BC117-02 | 100ul ×20 | 包 | |
| BC118-01 | Stable 感受态细胞 | 100ul ×20 | 包 |
| BC106-01 | DH10B 感受态细胞 | 100μl ×10 | 包 |
| BC106-02 | 100μl ×20 | 包 | |
| BC107-01 | OmniMAX2-T1 感受态细胞 | 100μl ×10 | 包 |
| BC107-02 | 100μl ×20 | 包 | |
| BC108-01 | Stbl3 感受态细胞 | 100μl ×20 | 包 |
| BC115-01 | Stbl4 感受态细胞 | 100μl ×20 | 包 |
| BC109-01 | XL10-Gold 感受态细胞 | 100μl ×20 | 包 |
| BC110-01 | JM110 感受态细胞 | 100μl ×20 | 包 |
| BC111-01 | DB3. 1 感受态细胞 | 100μl ×20 | 包 |
| BC112-01 | DH10BAC 感受态细胞 | 100μl ×20 | 包 |
| BC113-01 | NEB 10-beta 感受态细胞 | 100μl ×20 | 包 |
| BC114-01 | BJ5183-AD- 1 感受态细胞 | 100μl ×20 | 包 |
| E-2 、大肠杆菌表达感受态细胞 | |||
| 货号 | 产品名称 | 规格 | 单位 |
| BC201-01 | BL21(DE3) 感受态细胞 | 100μl ×10 | 包 |
| BC201-02 | 100μl ×20 | 包 | |
| BC202-01 | BL21(DE3) pLysS 感受态细胞 | 100μl ×10 | 包 |
| BC202-02 | 100μl ×20 | 包 | |
| BC203-01 | M15 感受态细胞 | 100μl ×10 | 包 |
| BC203-02 | 100μl ×20 | 包 | |
| BC204-01 | Rosetta(DE3) 感受态细胞 | 100μl ×10 | 包 |
| BC204-02 | 100μl ×20 | 包 | |
| BC205-01 | OrigamiB(DE3) 感受态细胞 | 100μl ×10 | 包 |
| BC205-02 | 100ul ×20 | 包 | |
| BC206-01 | T7 表达感受态细胞 | 100μl ×10 | 包 |
| BC206-02 | 100μl ×20 | 包 | |
| BC207-01 | T7pLysY 感受态细胞 | 100μl ×10 | 包 |
| BC207-02 | 100μl ×20 | 包 | |
| BC208-01 | Shuffle T7-K12 感受态细胞 | 100μl ×10 | 包 |
| BC208-02 | 100μl ×20 | 包 | |
| BC209-01 | Shuffle T7-B 感受态细胞 | 100μl ×10 | 包 |
| BC209-02 | 100μl ×20 | 包 | |
| E-3 大肠杆菌电转感受态细胞 | |||
| 货号 | 产品名称 | 规格 | 单位 |
| BC401-01 | NEB 10-beta 电转感受态细胞 | 50μl ×20 | 包 |
| BC402-01 | BJ5183 电转感受态细胞 | 50μl ×20 | 包 |
| BC403-01 | BJ5183-AD- 1 电转感受态细胞 | 50μl ×20 | 包 |
| BC404-01 | TOP10 电转感受态细胞 | 50μl ×20 | 包 |
| BC405-01 | DH5α 电转感受态细胞 | 50μl ×20 | 包 |
| E-4 农杆菌感受态细胞 | |||
| 货号 | 产品名称 | 规格 | 单位 |
| BC301-01 | LBA4404 农杆菌感受态细胞 | 100ul ×20 | 包 |
| BC302-01 | AGL1 农杆菌感受态细胞 | 100ul ×20 | 包 |
| BC303-01 | EHA105 农杆菌感受态细胞 | 100ul ×20 | 包 |
| BC304-01 | GV3101 农杆菌感受态细胞 | 100ul ×20 | 包 |
| E-5 、农杆菌电转感受态细胞 | |||
| 货号 | 产品名称 | 规格 | 单位 |
| BC305-01 | LBA4404 农杆菌电转感受态细胞 | 50μl ×20 | 包 |
| BC306-01 | AGL1 农杆菌电转感受电转态细胞 | 50μl ×20 | 包 |
| BC307-01 | EHA105 农杆菌电转感受态细胞 | 50μl ×20 | 包 |
| BC308-01 | GV3101 农杆菌电转感受态细胞 | 50μl ×20 | 包 |
风险提示:丁香通仅作为第三方平台,为商家信息发布提供平台空间。用户咨询产品时请注意保护个人信息及财产安全,合理判断,谨慎选购商品,商家和用户对交易行为负责。对于医疗器械类产品,请先查证核实企业经营资质和医疗器械产品注册证情况。
文献和实验
DH5α-大肠杆菌感受态细胞
实验目的1.了解转化的概念及其在分子生物学研究中的意义。2.学习氯化钙法制备大肠杆菌感受态细胞的方法。3.学习将外源质粒 DNA 转入受体菌细胞并筛选转化体的方法。实验原理转化( Transformation )是将异源 DNA 分子引入另一细胞品系,使受体细胞获得新的遗传性状的一种手段,它是微生物遗传、分子遗传、基因工程等研究的基本实验技术。转化中的受体细胞: 转化过程所用的受体细胞一般是限制性修饰系统缺陷的变异株,即不含限制性内切酶和甲基化酶的突变株,常用 RM 符号表示。转化方法:电击
相关专题 大肠杆菌的基因工程 Xl1-Blue菌株 基因型:endA1 gyrA96(nalR) thi-1 recA1 relA1 lac glnV44 F‘[Tn10 proAB+ lacIq Δ(lacZ)M15] hsdR17(rK- mK+)。 特点:具有卡那抗性、四环素抗性和氯霉素抗性。 用途:分子 克隆和质粒提取。 DH5α菌株 基因
4.操作步骤 1)大肠杆菌感受态细胞的制备(CaCl2法) (1) 从新活化的E.coli DH5α菌平板上挑取一单菌落,接种于3~5ml LB液体培养中,37℃振荡培养12h左右,直至对数生长期。将该菌悬液以1:100~1:50转接于100ml LB液体培养基中,37℃振荡扩大培养,当培养液开始出现混浊后,每隔20~30min测一次OD600nm,至OD600nm≤0.5时停止培养;(2) 每组取培养液3个2ml转入2ml离心管中,在冰上冷却20-30min,于4℃,4000r/
技术资料